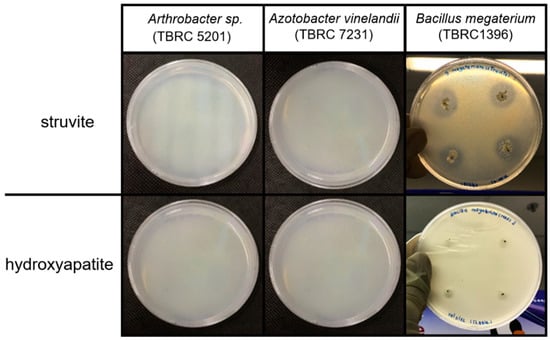

Abstract
Struvite and hydroxyapatite are byproducts of phosphorus removal from wastewater that can be used as phosphate fertilizers. Due to their low water solubility, especially in alkaline soils, their use is currently limited. The use of phosphate-solubilizing bacteria to enhance the dissolution of struvite and hydroxyapatite could be an attractive solution for expanding their use, but literature reports on this are limited. In this study, Arthrobacter sp. (TBRC 5201), Azotobacter vinelandii (TBRC 7231), and Bacillus megaterium (TBRC 1396) were evaluated for their ability to dissolve struvite and hydroxyapatite on agar media with struvite or hydroxyapatite as the sole source of phosphorus. Only B. megaterium (TBRC 1396) was able to use struvite and hydroxyapatite for growth. After 14 d of incubation in liquid medium, B. megaterium (TBRC 1396) dissolved phosphorus from struvite up to 835.45 ± 11.76 mg P/l compared with 196.08 ± 3.92 mg P/l in a control without cells, whereas the dissolution of hydroxyapatite by B. megaterium was minimal. B. megaterium (TBRC 1396) was also capable of dissolving phosphorus from swine wastewater-derived struvite. Both free cells and alginate-encapsulated cells of B. megaterium (TBRC 1396) were able to rapidly dissolve phosphorus from swine wastewater-derived struvite, resulting in soluble phosphorus concentrations that reached 400 mg P/l within 2 days, compared with those without cells that required 12 days. In conclusion, the application of struvite with phosphate-solubilizing bacteria is a promising tool for green sustainable agriculture.
1. Introduction
Wastewater from many food and livestock industries contains phosphorus. Removing phosphorus from wastewater is critical, because phosphorus can cause rapid growth of aquatic plants and algae (eutrophication) in water sources, negatively impacting the ecosystem. One approach that has received much attention is the recovery of phosphorus from wastewater by precipitation of phosphorus in the form of minerals such as struvite (MgNH4PO4.6H2O) and hydroxyapatite (Ca5(PO4)3(OH)) [1,2]. Phosphorus recovery from wastewater not only eliminates phosphorus pollution in water but also converts phosphorus from wastewater into products, such as P fertilizer, which fits perfectly with a circular economic model. Moreover, phosphate rock, which is the primary raw material for P fertilizer production, is a limited resource that is likely to be depleted within the next 70–140 years [3].
Struvite precipitation is widely used to recover nutrients from swine wastewater, landfill leachate, and urine, because it requires both ammonium and phosphate in wastewater for its precipitation [2]. On the other hand, hydroxyapatite is well-suited for wastewaters that have high phosphorus but low ammonium concentrations, such as effluents from anaerobic digesters in the PhoStrip processes [4], acidic industrial wastewater [5], and an effluent from an anaerobic sedimentation tank in the anaerobic-anoxic nitrifying two-sludge process [6].
Struvite is most commonly applied as a fertilizer in granular or powdered form in the field; however, it has very low water solubility compared to commercial P fertilizers such as ammonium phosphate and superphosphate. Struvite is typically considered a slow-release fertilizer, and its dissolution rate is dependent on the struvite characteristics and soil pH [7]. The dissolution of struvite in a granular form would likely be much slower than that of a powder mixed in the soil. Struvite effectiveness is favored in soils with acidic and near neutral pH [8,9], and its solubility decreases in alkaline soil [7]. Previous work has suggested that struvite from different origins may be utilized in different application routes [10]. Struvite obtained from dewatering liquor and the upflow anaerobic sludge blanket (USAB) may be suitable for blending into N-P-K fertilizers, and struvite obtained from the digestate of sewage waste-activated sludge is more suited for specialized applications (e.g., in growing media).
In soils, phosphate-solubilizing bacteria (PSB) are beneficial bacteria capable of producing low-molecular-weight organic acids whose hydroxyl and carboxyl groups chelate the cations bound to phosphate and convert insoluble compounds to soluble forms [11], thereby enhancing P availability in soil and P uptake by plants. A decrease in pH and an increase in P solubilization were noticeable in soil and broth media in the presence of PSB [12]. PSB have been widely used as phosphate biofertilizers in agriculture to increase the available phosphate content in soils. Many PSB strains belong to the genera Arthrobacter, Bacillus, Azotobacter, Pantoea, Enterobacter, Pseudomonas, Rhizobium, and Burkholderia [13,14,15,16].
Cell immobilization and encapsulation have been widely used to achieve protective cells due to limited exposure to adverse environmental factors, relatively stable cells, and potentially enhanced viability and stability [17]. Microbial encapsulation also shows advantages over liquid inoculants for agricultural purposes, because liquid inoculants are unable to offer protection against biotic and abiotic soil stresses. The encapsulation of PSB by alginate beads for agricultural applications has already been demonstrated [17].
Although struvite and hydroxyapatite precipitation from wastewater is a well-established method for recovering phosphorus, their low solubility limits their use as fertilizers, particularly in alkaline soils. Despite the widespread use of PSB in agriculture, until now, there has only been one study investigating their ability to enhance P solubilization from struvite, which reported that B. megaterium combined with struvite increased dry matter yield at harvest of the plant compared to struvite alone, particularly in low-P soil [18]. Nevertheless, the extent of microbially mediated P solubilization from struvite has still not been quantified. In addition, information on the performance of different cell applications, i.e., free cells versus encapsulated cells, is still lacking. Moreover, although hydroxyapatite is not commonly used as a P fertilizer due to its extremely low solubility, the application of PSB could improve this property. However, until now, there have been only a few PSB, namely, Serratia marcescens CTM 50650, Azotobacter spp., and Enterobacter agglomerans, that have been reported to enhance P solubilization from hydroxyapatite [19,20,21,22].
Swine wastewater output has exponentially and globally increased to meet the increasing demand for proteins [23]. The wastewater produced in swine farms is rich in ammonia and phosphorous with high eutrophication potential and negative environmental impacts. The recovery of N and P from swine wastewater has therefore attracted our research attention. The aim of this study was to assess the potential of PSB to enhance the dissolution of struvite obtained from swine wastewater and to determine how encapsulation affects the dissolution and microbiological aspects. To the best of the authors’ knowledge, this is the first study that has quantified PSB-mediated P dissolution from wastewater-derived struvite using free cells and encapsulated cells. In addition, hydroxyapatite dissolution by PSB was also investigated in this study. The results from this study could help expand the use of wastewater-derived phosphorus minerals as fertilizers, especially in alkaline soils in which P dissolution is usually low.
2. Materials and Methods
2.1. Preparation of Bacterial Cultures
Three strains of bacteria, Arthrobacter sp. (TBRC 5201), Azotobacter vinelandii (TBRC 7231), and Bacillus megaterium (TBRC1396), were purchased from the Thailand Bioresource Research Center (TBRC). These selected bacterial species are PSB that have been reported in previous studies as being able to enhance the dissolution of phosphate minerals, such as tricalcium phosphate, hydroxyapatite, iron phosphate, and aluminum phosphate [11,24,25]. In addition, all of these strains are nonpathogenic bacteria that can be used in biosafety level 1 laboratories. Colonies of the three strains were grown on nutrient agar (NA) (Difco™, Fisher Scientific, Hampton, NH, USA) in triplicate for 24 h at 30 °C. The bacterial cultures were then stored at 4 °C before being transferred to 400 mL of nutrient broth (NB) (Difco™, Fisher Scientific, USA). The broth cultures were grown at 30 °C for 16–18 h in a shaker incubator at a speed of 150 rpm until the bacterial concentration reached approximately 106 CFU/mL.
2.2. Screening of Bacterial Capabilities for Struvite and Hydroxyapatite Dissolution
Bacterial cultures (2 µL) were transferred to National Botanical Research Institute phosphate (NBRIP) agar growth medium (Table S1) with the addition of two different phosphate sources, namely, struvite (MgNH4PO4.6H2O) and hydroxyapatite (Ca5(PO4)3OH) [26], (see Supplementary Materials). Struvite and hydroxyapatite were purchased from Alfa Aesar, Haverhill, MA, USA, and Sigma–Aldrich, St. Louis, MO, USA, respectively. The spot inoculation method [27] was performed with four spots per agar plate. Then, the cultures were incubated at 30 °C for 7 days. Experiments were performed in triplicate. Clear zones around bacterial colonies that indicated the ability of bacteria to dissolve phosphate minerals were observed for 7 days. The phosphate solubilization index (PSI) was determined by measuring the diameters of the colonies and the corresponding clear zones, where PSI = total diameter (colony + clear zone)/diameter of colony [28], as shown in Figure S1.
2.3. Struvite and Hydroxyapatite Dissolution by B. megaterium (TBRC 1396)
The NB culture of B. megaterium (TBRC 1396) was transferred to NBRIP liquid culture medium with the addition of struvite (Alfa Aesar, USA) or hydroxyapatite (Sigma–Aldrich, USA) (Table S1). The bacterial culture was diluted from 106 CFU/mL to an initial concentration of 102 CFU/mL. Cultures were then incubated in a shaking incubator at 30 °C for 14 days at 150 rpm. Experiments were performed in triplicate. Controls without the addition of bacteria were also tested in triplicate. Samples were taken daily for measurement of bacterial growth, soluble phosphorus concentration, and pH. Bacterial growth was measured by the standard plate count method. The pH was measured using a pH meter (SevenEasy, Mettler Toledo, Switzerland). For the measurements of soluble phosphorus and organic acids, samples were centrifuged at 10,000 rpm for 15 min at 4 °C (Allegra® X-I5R Centrifuge, Beckman Coulter, Brea, CA, USA). The supernatant was filtered through a 0.22-µm syringe filter to separate the cells and any residual phosphate minerals. The soluble phosphate was measured at 882 nm by a UV/Vis spectrophotometer (Thermo Spectronic Genesys 20, Thermo Electron Corporation, Waltham, MA, USA) using the molybdenum blue method [17,29,30]. Organic acid concentrations at the highest phosphorus dissolution rate, which was after 2 d of incubation, were analyzed by high-performance liquid chromatography (HPLC) with a photodiode detector equipped with an Aminex HPX-87H 1290 column (Agilent, Santa Clara, CA, USA).
2.4. Struvite Precipitation from Swine Wastewater and Its Characterization
The wastewater for struvite precipitation was collected from the effluent of an anaerobic bioreactor treating swine wastewater at the Prachafarm pig farm, Nakhon Pathom, Thailand, and was preserved at 4 °C until further processing. The concentrations of PO43−, Mg2+, and NH4+ were determined by the vanadomolybdophosphoric acid colorimetric method, nitric acid hydrochloric acid digestion with the inductively coupled plasma (ICP) method, and the titrimetric method [31], respectively. The pH of the wastewater was measured using a pH meter (SevenEasy, Mettler Toledo, Switzerland). The molar ratio of Mg2+:NH4+:PO43− was then adjusted to a ratio of 1:1:1 by adding MgCl2.6H2O (Kemaus, Cherrybrook, NSW, Australia) and NaH2PO4.2H2O (Kemaus, Australia) for additional Mg2+ and PO43−, respectively. This molar ratio has been shown to be suitable for struvite precipitation [32]. The pH of the mixed solution was adjusted with NaOH (Carlo Erba Reagents, Cornaredo, Italy) to 7.5, 8, 8.5, or 9, as these were found to be suitable for the precipitation of struvite [32]. The mixture was stirred by rapid mixing at 240 rpm for 10 min, followed by slow mixing at 120 rpm for 15 min. The struvite precipitates were collected after 24 h using 0.45-µm filters with a vacuum pump and kept in a desiccator for 48 h. Subsequently, the obtained struvite precipitates were analyzed for their crystal structures by X-ray diffraction (XRD) (D8 advance, Bruker, Germany). The Mg, P, and O compositions in the struvite were analyzed by scanning electron microscopy (SEM–EDS) (JEOL JSM-IT300, Tokyo, Japan; Oxford X-Max 20, UK). NH4+ composition was determined by dissolving struvite at a pH of 5, and NH4+ concentrations in the solutions were measured by the salicylic method [33]. A heterogeneous powder of struvite precipitates was crushed and sieved through a 0.149 mm mesh sieve. A particle size analyzer (Nanotrac Wave II, Microtrac MRB, Montgomeryville, PA, USA) was used for the particle size measurement.
2.5. Dissolution of Swine Wastewater-Derived Struvite Using B. megaterium (TBRC 1396)
The NB culture of B. megaterium (TBRC 1396) was transferred to NBRIP liquid culture medium with the addition of struvite precipitated from swine wastewater at pH 8. Assays were performed in triplicate along with controls without cells in a similar manner as described in Section 2.3 with the initial cell concentrations of B. megaterium (TBRC 1396) at approximately 102 CFU/mL. Bacterial growth, pH, and soluble phosphorus were measured daily, and organic acids were analyzed after 2 d of incubation when phosphorus dissolution rates were highest.
2.6. Applications of Free Cells and Encapsulated Cells for the Dissolution of Swine Wastewater-Derived Struvite
For the preparation of encapsulated cells, a single colony of B. megaterium (TBRC 1396) was transferred to 2000 mL of NB liquid culture medium and grown in a shaking incubator at a speed of 120 rpm and a temperature of 30 °C for 16–18 h to achieve a bacterial concentration of approximately 106 CFU/mL. Subsequently, the bacterial culture was centrifuged at 10,000 rpm at 4 °C for 15 min (Allegra® X-I5R Centrifuge, Beckman Coulter, USA). The cell pellets were collected and rinsed twice with 0.85% NaCl (Kemaus, Australia). The bacterial cells were stored in 0.85% NaCl, which was then used to prepare encapsulated cells by transfer into 2% sodium alginate (Sigma–Aldrich, USA). The solution was then passed through a syringe needle (diameter 0.6 mm) into a 2% CaCl2 (Kemaus, Australia) solution. The alginate beads were collected after 30 min and rinsed twice with 500 mL of DI water. The alginate beads were then stored in a 0.1% peptone buffer solution (Himedia, Thane, India). The encapsulation efficiency was calculated according to Afzaal et al. (2019) [34].
The dissolution of struvite by free cells and encapsulated cells of B. megaterium (TBRC 1396) was performed in triplicate with controls in the absence of cells. Alginate beads without cells were prepared as controls for the experiment with encapsulated cells. The initial cell concentrations for both free cells and encapsulated cells were set approximately equally at 105 CFU/mL for comparison purposes. Free cells and encapsulated NB cultures of B. megaterium (TBRC 1396) were transferred to NBRIP liquid culture medium with the addition of struvite precipitated from swine wastewater at pH 8. The experiment was conducted as described in Section 2.3, and bacterial growth, pH, and soluble phosphorus were measured every day. Organic acid concentrations were measured after 2 d. For measurement of cell concentrations in the alginate beads, the encapsulated cell samples were collected and dissolved in a phosphate buffer solution (pH of 7.5) and shaken in a water bath at 250 rpm at 30 °C for 30 min or until all alginate beads were dissolved. The number of cells in the suspension was then quantified using the standard plate count method. Subsequently, the dissolution of struvite by free cells and encapsulated cells of B. megaterium (TBRC 1396) was statistically compared using IBM® SPSS® software (New York, NY, USA).
3. Results and Discussion
3.1. Screening of Bacterial Capabilities for Struvite and Hydroxyapatite Dissolution
The screening of PSB, Arthrobacter sp. (TBRC 5201), Azotobacter vinelandii (TBRC 7231), and Bacillus megaterium (TBRC 1396) for their ability to enhance struvite and hydroxyapatite dissolution was performed on NBRIP agar media supplemented with struvite or hydroxyapatite.
Arthrobacter sp. (TBRC 5201) and Azotobacter vinelandii (TBRC 7231) were unable to grow on NBRIP agar media containing struvite or hydroxyapatite as phosphorus sources. None of the colonies were observed on NBRIP agar (Figure 1), indicating that they are incapable of dissolving phosphate from struvite and hydroxyapatite to be used for growth. In contrast, B. megaterium (TBRC 1396) was able to grow on NBRIP agar media containing struvite or hydroxyapatite as phosphorus sources (Figure 1).
Figure 1.
Screening of PSB (Arthrobacter sp. (TBRC 5201), Azotobacter vinelandii (TBRC 7231), and Bacillus megaterium (TBRC 1396) on NBRIP agar growth medium to assess their capabilities of dissolving struvite and hydroxyapatite.
In addition, distinct clear zones were observed around the colonies on the NBRIP agar plates with struvite as the phosphorus source, indicating that B. megaterium (TBRC 1396) can dissolve phosphate from struvite remarkably well. In B. megaterium (TBRC 1396) cultured on NBRIP agar medium with hydroxyapatite as the phosphate source, no clear zones were observed despite the formation of colonies. The results suggest that B. megaterium (TBRC 1396) can dissolve a limited amount of phosphorus from hydroxyapatite to support growth, but not enough to produce distinct clear zones on the culture medium.
Furthermore, the PSI values indicating the ability to dissolve phosphate from P minerals were estimated from colony and clear zone measurements. The PSI can be classified into three levels: low, with a PSI less than two; moderate, with a PSI between two and four; and high, with a PSI above four [35]. According to the PSI observed, B. megaterium (TBRC 1396) has a moderate ability to dissolve struvite, with a PSI of 2.72 ± 0.31. On the other hand, this bacterium has a low ability to dissolve hydroxyapatite, with a PSI of 1.00 ± 0.00. The results of the experiments are shown in Figure 2 and Table S2.

Figure 2.
Phosphate solubilization index (PSI) values of B. megaterium (TBRC 1396) indicate its capabilities for struvite and hydroxyapatite dissolution.
Of the three PSB, Arthrobacter sp. (TBRC 5201), Azotobacter vinelandii (TBRC 7231), and B. megaterium (TBRC 1396), only B. megaterium (TBRC 1396) was able to dissolve struvite and hydroxyapatite. However, in contrast to our results, a previous study by Reyes et al. (2006) [20] showed that Azotobacter spp. isolated from the rhizosphere of colonizer plants at an abandoned rock phosphate mine could dissolve hydroxyapatite when using glucose, sucrose, and/or mannitol as carbon sources and ammonia and/or nitrate as nitrogen sources. Nevertheless, the species and strains of Azotobacter used in this study and in Reyes et al. (2006) [20] were likely different, resulting in different abilities to dissolve hydroxyapatite.
3.2. Struvite Dissolution by B. megaterium (TBRC 1396)
B. megaterium (TBRC 1396), the PSB with the highest potential for P mineral dissolution as observed in the screening assay, was cultured for 14 days in NBRIP liquid culture medium with the addition of struvite or hydroxyapatite. Figure 3 shows the results of struvite dissolution by B. megaterium (TBRC 1396) along with the control in the absence of cells. B. megaterium (TBRC 1396) was found to be capable of dissolving struvite in the NBRIP liquid culture medium. The initial concentration of soluble phosphorus in the culture medium was 110.75 ± 1.67 mg P/l, and it increased to 295.05 ± 12.92 mg P/l after two days. Then, it continued to dissolve and reached a soluble phosphorus concentration of 794.67 ± 18.29 mg P/l after 7 days and gradually increased to 835.45 ± 11.76 mg P/l after 14 days. In contrast, in the control without cells, struvite could dissolve to a certain extent from 99.30 ±7.99 mg P/l to 196.08 ± 3.92 mg P/l over 14 days. The results obtained in this study are in agreement with those of Hernández Jiménez et al. (2021) [18], who found that in a greenhouse study, B. megaterium combined with struvite resulted in a higher crop yield with more N and P uptake than that with struvite alone in a low-P soil.

Figure 3.
Soluble phosphate concentrations (mg P/l), pH (a), and viable cell concentrations (CFU/mL) (b) in the tests for struvite dissolution in the presence of B. megaterium (TBRC 1396) along with the controls without cells and organic acid concentrations after 2 d of B. megaterium (TBRC 1396) incubation (c).
The presence of B. megaterium (TBRC 1396) resulted in a decrease in the pH of the culture medium from an initial pH of 6.93 ± 0.03 to 4.91 ± 0.11 after 14 days of incubation. In contrast, the control without cells had a slight decrease in pH from 6.79 ± 0.01 to 6.67 ± 0.03 after 14 days. From the initial cell concentrations of approximately 100 CFU/mL, there was a rapid increase in cell concentrations of B. megaterium (TBRC 1396) to 4.15 × 105 CFU/mL after one day, and cell concentrations reached a maximum of 107 CFU/mL after 5 days of incubation. Thereafter, cell concentrations gradually decreased due to substrate limitation in batch cultures.
Four organic acids, i.e., acetic acid, lactic acid, gluconic acid, and malic acid, were detected in the liquid culture of B. megaterium (TBRC 1396) after two days of incubation (Figure 3). The production of organic acids is likely to play a significant role in struvite dissolution by PSB. In a previous study, Talboys et al. (2016) [36] hypothesized that organic acids released by plant roots increase struvite solubility. Thus, the dissolution of struvite by organic acids (acetic acid, malic acid, oxalic acid, and citric acid) was compared to a control containing no organic acids. Compared to the control, significant increases in phosphorus dissolution from struvite by organic acids were observed [36], indicating the ability of organic acids to dissolve phosphorus from struvite.
The mechanisms of phosphate dissolution by PSB generally involve the production of organic acids from carbon sources, such as glucose, via the direct oxidation pathway. The hydroxyl and carboxyl groups of these organic acids can then chelate with the cations in phosphate minerals, such as Ca, Fe, and Al, releasing soluble phosphate [37]. In the case of struvite, the organic acids were likely chelated with Mg. Nevertheless, secretion of organic acids is not the only mechanism for phosphorus dissolution by PSB, as shown by the higher P solubilization in the presence of PSB compared to that in the presence of organic acids at similar pH values [22,38]. Exopolysaccharide (EPS) production is another mechanism utilized by PSB to dissolve phosphorus minerals, as EPSs can bind with cations bound to phosphate, resulting in more soluble phosphorus [39]. In addition, pH decreases by H+ excretion, which are generally associated with ammonia assimilation and H2CO3 production from respiration, can also promote the dissolution of phosphate minerals [39].
3.3. Hydroxyapatite Dissolution by B. megaterium (TBRC 1396)
The results of the dissolution of hydroxyapatite by B. megaterium (TBRC 1396) and its control are shown in Figure 4. B. megaterium (TBRC 1396) exhibited a very low ability to dissolve hydroxyapatite in NBRIP liquid culture medium. The initial soluble phosphorus in the culture medium was 4.73 ± 2.28 mg P/l and reached 11.90 ± 1.95 mg P/l after two days of incubation. Thereafter, it continued to dissolve and reached its maximum solubility at 32.54 ± 1.49 mg P/l after 14 days. The results are consistent with the results of the screening test using NBRIP agar medium, in which B. megaterium (TBRC 1396) was able to dissolve a small amount of hydroxyapatite to support its growth, but not a sufficiently high enough amount to detect the clear zones around the colonies.

Figure 4.
Soluble phosphate concentrations (mg P/l), pH (a), and viable cell concentrations (CFU/mL) (b) in the tests for hydroxyapatite dissolution in the presence of B. megaterium (TBRC 1396) along with the controls without cells and organic acid concentrations after 2 d of B. megaterium (TBRC 1396) incubation (c).
In the presence of B. megaterium (TBRC 1396), the pH in the culture medium decreased from 6.28 ± 0.08 to 4.69 ± 0.04 after 14 days of incubation (Figure 4). In contrast, the pH in the control without cells remained approximately the same throughout the incubation period. The cell concentrations of B. megaterium (TBRC 1396) in the medium with hydroxyapatite reached the highest at 1.59 × 106 CFU/mL after 5 days of incubation, which was lower than that in the medium with struvite.
In addition, B. megaterium (TBRC 1396) produced three organic acids, lactic acid, citric acid, and gluconic acid, in the NBRIP liquid culture medium with hydroxyapatite as the phosphorus source (Figure 4). The organic acids produced were different from those obtained when struvite was used as the phosphorus source. Despite the production of organic acids, only a very small amount of phosphorus was dissolved from hydroxyapatite by B. megaterium (TBRC 1396), which could be due to its extremely low solubility of hydroxyapatite (Ksp = 2.35 × 10−59) [2].
Notably, other PSB, including Azotobacter spp., Serratia marcescens CTM 50650, and Enterobacter agglomerans, have been previously reported to dissolve hydroxyapatite [19,20,21,22]. Under optimal conditions, S. marcescens CTM 50650 can dissolve hydroxyapatite, releasing up to 595 mg P/l soluble phosphorus, which was much higher than that obtained by B. megaterium (TBRC 1396) in this study.
3.4. Struvite Precipitation from Swine Wastewater and Its Characterization
The struvite precipitated from swine wastewater was opaque with a light brown color and was in the form of a lumpy powder (Figure S2). The amount of struvite precipitate increased with an increasing pH (7.5, 8.0, 8.5, and 9.0) (Table S3), since the solubility of struvite decreases with an increasing pH [40].
Crystal structure analysis of struvite precipitates from swine wastewater at pH 7.5, 8.0, 8.5, and 9.0 by XRD showed that all precipitates had the same crystal structures as struvite (MgNH4PO4.6H2O) according to the XRD database and were consistent with commercial struvite (Figure 5). Therefore, it can be concluded that the precipitates obtained from swine wastewater are struvite. In addition, the percent figure of merit (%FOM) (the higher the %FOM, the better the match), crystal size, and the degree of crystallinity were determined. It was found that the struvite precipitate at pH 8.0 had the crystal size and %FOM value closest to those of the struvite values in the database. This precipitate also had a crystal size of 79.55 nm and a %FOM of 87.20%, which are close to the crystal size and %FOM of commercial struvite; these are 75.06 nm and 88.95%, respectively. All precipitates at pH 7.5, 8.0, 8.5, and 9.0 had a degree of crystallinity ranging from 91.00–91.60%.

Figure 5.
XRD diffractograms of commercial struvite and swine wastewater-derived struvite at pH 7.5, 8.0, 8.5, and 9.0.
Elemental analysis by SEM–EDS of precipitates from swine wastewater at pH 7.5, 8.0, 8.5, and 9.0 showed that the precipitates did not differ significantly in composition. All precipitates were mainly composed of oxygen, magnesium, and phosphorus, all of which are the major constituents of struvite (MgNH4PO4.6H2O) (Table S4). From the results, the average molar ratio of P and Mg was 1.03 ± 0.0618, which is close to the theoretical molar ratio of 1:1. However, the SEM–EDS analysis did not detect nitrogen in either the struvite precipitated from swine wastewater or in commercial struvite. The lack of nitrogen detection by SEM–EDS could indicate that the element is not on the surface of the struvite but rather deep within the struvite, and thus cannot be analyzed using EDS techniques. We then determined the amount of nitrogen by dissolving the struvite in acid at pH 5 and measuring the ammonium in the solution. It was found that the nitrogen content in the struvite precipitated at pH 7.5, 8.0, 8.5, and 9.0 was 0.054, 0.044, 0.039, and 0.039 g N/g struvite, respectively, which is lower than but somewhat close to the theoretical nitrogen content of struvite of 0.057 g N/g struvite.
The struvite precipitate at pH 8.0 has the properties that are closest to struvite in the database and in commercial struvite, especially in terms of crystal size and %FOM. Therefore, this precipitate was used for further experiments. In addition, the particle sizes of the struvite precipitated from swine wastewater at pH 8 and the commercial struvite used in this study were examined and found to be 3.62 ± 2.532 µm and 1.029 ± 0.519 µm, respectively. Notably, the particle sizes of the struvite used in this study were smaller than those of struvite produced in fluidized-bed reactors (12–1000 µm), which is commonly used in industry [41,42].
3.5. Dissolution of Swine Wastewater-Derived Struvite Using B. megaterium (TBRC 1396)
B. megaterium (TBRC 1396) was tested for its ability to dissolve the struvite precipitated from swine wastewater at pH 8 in NBRIP liquid culture medium. Concentrations of soluble phosphorus, viable cells, and pH were monitored for 14 days. The results showed that B. megaterium (TBRC 1396) increased struvite solubility from the second day of incubation and continuously improved struvite solubility over a 14-day period (Figure 6). The soluble phosphorus concentration increased from 231.92 ± 2.27 mg P/l to 506.08 ± 3.94 mg P/l after two days. The concentration of soluble phosphorus then gradually increased and reached a maximum of 794.89 ± 7.87 mg P/l after 5 days and remained constant thereafter.

Figure 6.
Soluble phosphate concentrations (mg P/l), pH (a), and viable cell concentrations (CFU/mL) (b) in the tests for the dissolution of swine wastewater-derived struvite in the presence of B. megaterium (TBRC 1396) along with the controls without cells and organic acid concentrations after 2 d of B. megaterium (TBRC 1396) incubation (c).
In contrast, struvite dissolved slowly in the controls without B. megaterium (TBRC 1396), and the concentration of soluble phosphorus reached 392.03 ± 0.79 mg P/l after 14 days, which could be achieved within 1–2 days in the presence of B. megaterium (TBRC 1396). The results clearly indicate that B. megaterium (TBRC 1396) can accelerate the dissolution of swine wastewater-derived struvite compared to the control in the absence of B. megaterium (TBRC 1396). Notably, there appears to be a difference in the solubility of commercial struvite and swine wastewater-derived struvite both in the absence and presence of B. megaterium (TBRC 1396), which could be due to the differences in morphology and particle sizes of struvite obtained from different sources [10].
The pH in the tests with swine wastewater-derived struvite inoculated with B. megaterium (TBRC 1396) gradually decreased from 6.41 ± 0.01 to 4.76 ± 0.08 over 14 days, whereas the control without cells showed a slight decrease in pH from 6.56 ± 0.00 to 6.41 ± 0.02 over 14 days (Figure 6). The results clearly indicate that B. megaterium (TBRC 1396) was responsible for the decrease in pH.
The Initial concentration of viable cells was approximately 100 CFU/mL, and then it increased rapidly to 1.56 × 107 CFU/mL after one day (Figure 6). After two days, the cell concentration began to decrease and was 3.19 × 105 CFU/mL after 14 days.
In addition, the secretion of organic acids by B. megaterium (TBRC 1396) was analyzed after two days of incubation when the phosphate dissolution rate was highest. Four types of organic acids were found in the tests, including acetic acid, lactic acid, gluconic acid, and malic acid (Figure 6). B. megaterium (TBRC 1396) was found to produce the same organic acids when using commercial struvite and swine wastewater-derived struvite. However, the amount of each organic acid was different. For both cases, lactic acid was found in the highest concentrations compared to other organic acids, which were 3.930 mM and 15.129 mM for the commercial struvite and the struvite from swine wastewater, respectively, after two days of incubation.
A previous study by Chen et al. (2006) [11] reported the secretion of organic acids, including lactic, citric, and propionic acids, by B. megaterium spp. isolated from a subtropical soil (from central Taiwan) in NBRIP media with tricalcium phosphate after 3 days of incubation. On the other hand, malic acid and quinic acid were secreted by B. megaterium mj1212 after 4 d of incubation in the same media (NBRIP) with tricalcium phosphate [43], suggesting that organic acid production appears to vary among the different B. megaterium strains despite the use of the same phosphate mineral and carbon source. The secretion of organic acids observed in Chen et al. (2006) [11] and Kang et al. (2014) [43] also differed from that observed in our study using B. megaterium (TBRC 1396) and struvite as the phosphate source. In addition, the incubation period is another factor that affects the profiles of organic acids produced by Bacillus spp. [44]. Since various organic acids possess different chelating potentials with cations bound to phosphate [45], research on the optimal conditions for organic acid production is further needed.
3.6. Applications of Free Cells and Encapsulated Cells for the Dissolution of Swine Wastewater-Derived Struvite
B. megaterium (TBRC 1396) cells were encapsulated in alginate beads ~3 mm in diameter (Figure S3). The encapsulation efficiency of B. megaterium (TBRC 1396) in alginate beads was 89.12 ± 0.92% (Table S5). Figure 7 shows the dissolution of swine wastewater-derived struvite using free cells and encapsulated cells of B. megaterium (TBRC 1396) compared to the controls without cells. The results clearly show that both free cells and encapsulated cells of B. megaterium (TBRC 1396) improve struvite dissolution compared to the controls, with the free cells achieving significantly higher soluble phosphorus than the encapsulated cells after one day of incubation (p < 0.01). The soluble phosphorus concentrations increased to 780.54 ± 12.15 mg P/l and 589.10 ± 5.40 mg P/l for the free cells and encapsulated cells, respectively, within 14 days. The pH similarly decreased in the cultures with free and encapsulated cells from 6.39 ± 0.01 and 6.37 ± 0.01 to 4.95 ± 0.05 and 4.83 ± 0.03, respectively.

Figure 7.
Soluble phosphate concentrations (mg P/l) (a), pH (b), and viable cell concentrations (CFU/mL) (c) in the tests for struvite dissolution in the presence of encapsulated B. megaterium (TBRC 1396) and free cells of B. megaterium (TBRC 1396), along with the controls without cells and organic acid concentrations after 2 d of B. megaterium (TBRC 1396) incubation (d).
Notably, the conditions used in this study were suitable for cell growth. No stressful environments were introduced to the cells. Therefore, it is expected that free cells would be more efficient at enhancing phosphorus dissolution from struvite. The results on organic acid concentrations in the bulk solutions after two days of incubation also show that much higher organic acid concentrations were observed in the free cell cultures (total organic acids of 19.911 mmol/l) compared to the encapsulated cell cultures (total organic acids of 5.459 mmol/l) (Figure 7), suggesting that the encapsulating material used in this study (alginate) partially hindered the mass transfer of organic acids into the bulk solution. However, despite the low concentrations of organic acids in the bulk solution, the encapsulated PSB still significantly enhanced phosphorus dissolution from struvite precipitated from swine wastewater compared to the controls without cells.
Nevertheless, encapsulation of PSB could be beneficial for maintaining cell viability in practical applications in soils with potentially stressful environments. It has been reported that encapsulation by alginate beads can stabilize the viability of B. megaterium MB1 in a toxic environment (mercury contamination) compared to free cells [46]. In addition, encapsulation of B. megaterium in alginate microcapsules has been shown to protect cells from the bactericidal effects of ultraviolet radiation [47].
It should be noted that in this experiment, the initial free cell concentrations of B. megaterium (TBRC 1396) were ~105 CFU/mL, which was higher than those in the experiment performed in Section 3.5—Dissolution of swine wastewater-derived struvite using B. megaterium (TBRC 1396), in which the initial free cell concentrations were ~102 CFU/mL. However, the results were quite similar for both initial cell concentrations, as cell concentrations increased rapidly to ~107 CFU/mL in both cases and behaved similarly thereafter.
3.7. Implications and Future Research
The results of this study clearly demonstrate the ability of B. megaterium (TBRC 1396) to enhance the dissolution of struvite, both commercial struvite and swine wastewater-derived struvite. In addition, both free cells and encapsulated cells of B. megaterium resulted in significantly enhanced dissolution of swine wastewater-derived struvite.
Although precipitation of struvite and hydroxyapatite from wastewater has long been considered a well-developed approach for recovering phosphorus from wastewater, their actual application in agricultural practice as P fertilizers is limited due to their low solubility. In addition, the fertilizer potential of struvite is limited by its soil pH-dependent solubility, crop-specific interactions, and limited availability of struvite-derived nitrogen [48]. Struvite is more effective in acidic and near-neutral pH soils [8,9]; the crop response to struvite decreases with increasing pH [48], limiting its use in alkaline soils. The results of this study show that the use of PSB can improve the dissolution of struvite, which may aid in expanding its application, particularly in alkaline soils in which its low solubility is a concern. By increasing the use of struvite, the recovery of phosphorus from wastewater will eventually become plausible and desirable.
However, research on the use of PSB to enhance struvite and hydroxyapatite dissolution is still at an early stage, and further studies are needed, for example, on the ability of other PSB to enhance struvite and hydroxyapatite dissolution. Further studies are still required to determine the details of PSB application, such as a single culture vs. mixed cultures, free cells vs. encapsulated cells with various encapsulation materials, the suitable amount of PSB used, and the most appropriate PSB growth stages, which affect organic acid secretion. In addition, since the particle size of struvite could influence the rate and extent of struvite dissolution, further research is needed to elucidate the effects of particle size on struvite dissolution by PSB. Moreover, greenhouse and field studies are necessary, particularly to determine which plants and soil conditions would benefit from this application. Furthermore, life cycle analysis and cost–benefit analysis of the PSB application would also be beneficial in fully comprehending this technology.
4. Conclusions
Arthrobacter sp. (TBRC 5201) and Azotobacter vinelandii (TBRC 7231) were unable to use struvite or hydroxyapatite as the sole source of phosphorus for their growth. In contrast, B. megaterium (TBRC 1396) was able to grow on struvite or hydroxyapatite as the sole phosphorus source. B. megaterium (TBRC 1396) significantly improved the dissolution of both commercial struvite and swine wastewater-derived struvite. However, the dissolution of hydroxyapatite was only slightly improved by B. megaterium (TBRC 1396). Encapsulated cells of B. megaterium (TBRC 1396) in alginate beads enhanced struvite dissolution up to 589.10 ± 5.40 mg P/l after 14 days of incubation in liquid medium, compared to 780.54 ± 12.15 mg P/l when free cells of B. megaterium (TBRC 1396) were used at approximately the same initial cell concentrations.
Supplementary Materials
The following supporting information can be downloaded at: https://www.mdpi.com/article/10.3390/su141912627/s1, Table S1 Compositions of the NBRIP medium; Table S2 PSI values of struvite and hydroxyapatite dissolution by B. megaterium (TBRC 1396); Table S3 Characterization of struvite synthesized from swine wastewater and commercial struvite; Table S4 Elements in struvite precipitated from swine wastewater; Table S5 The efficiency of cell encapsulation by sodium alginate; Figure S1 Estimation of phosphate solubilization index (PSI); Figure S2 Struvite precipitated from swine wastewater; Figure S3 Immobilized cell of B. megaterium (TBRC 1396) (a) and immobilized cell of B. megaterium (TBRC 1396) at 50× magnification (b).
Author Contributions
Conceptualization, B.B.S. and C.C.; Methodology, B.B.S. and C.C.; Investigation, S.J. and C.P.; Resources, B.B.S. and C.C.; Data Curation, S.J. and K.J.; Writing—Original Draft Preparation, S.J. and K.J.; Writing—Review and Editing, C.P., C.C., and B.B.S.; Supervision, B.B.S. and C.C.; Funding Acquisition, B.B.S. and C.C. All authors have read and agreed to the published version of the manuscript.
Funding
This research was supported by the Research Network Nanotec (RNN) program of the National Nanotechnology Center (NANOTEC) and the Thailand Graduate Institute of Science and Technology (TGIST), NSTDA, Ministry of Higher Education, Science, Research and Innovation.
Acknowledgments
The authors would like to thank the Prachafarm pig farm, Nakhon Pathom Province, Thailand, for providing the swine wastewater used in this study. We also thank Chotikoon Bunditboondee for his assistance in the particle size measurement.
Conflicts of Interest
The authors declare no conflict of interest.
References
- Le Corre, K.S.; Valsami-Jones, E.; Hobbs, P.; Parsons, S.A. Phosphorus recovery from wastewater by struvite crystallization: A review. Crit. Rev. Environ. Sci. Technol. 2009, 39, 433–477. [Google Scholar] [CrossRef]
- Dai, H.; Tan, X.; Zhu, H.; Sun, T.; Wang, X. Effects of commonly occurring metal ions on hydroxyapatite crystallization for phosphorus recovery from wastewater. Water 2018, 10, 1619. [Google Scholar] [CrossRef]
- Li, B.; Boiarkina, I.; Young, B.; Yu, W.; Singhal, N. Prediction of future phosphate rock: A demand-based model. J. Environ. Inform. 2018, 31, 1–13. [Google Scholar] [CrossRef]
- Perera, M.K.; Englehardt, J.D.; Dvorak, A.C. Technologies for recovering nutrients from wastewater: A critical review. Environ. Eng. Sci. 2019, 36, 511–529. [Google Scholar] [CrossRef]
- Cichy, B.; Kuzdzal, E.; Krzton, H. Phosphorus recovery from acidic wastewater by hydroxyapatite precipitation. J. Environ. Manage. 2019, 232, 421–427. [Google Scholar] [CrossRef]
- Dai, H.; Lu, X.; Peng, Y.; Zou, H.; Shi, J. An efficient approach for phosphorus recovery from wastewater using series-coupled air-agitated crystallization reactors. Chemosphere 2016, 165, 211–220. [Google Scholar] [CrossRef]
- Degryse, F.; Baird, R.; da Silva, R.C.; McLaughlin, M.J. Dissolution rate and agronomic effectiveness of struvite fertilizers—Effect of soil pH, granulation and base excess. Plant Soil. 2017, 410, 139–152. [Google Scholar] [CrossRef]
- Uysal, A.; Yilmazel, Y.D.; Demirer, G.N. The determination of fertilizer quality of the formed struvite from effluent of a sewage sludge anaerobic digester. J. Hazard. Mater. 2010, 181, 248–254. [Google Scholar] [CrossRef]
- Cabeza, R.; Steingrobe, B.; Römer, W.; Claassen, N. Effectiveness of recycled P products as P fertilizers, as evaluated in pot experiments. Nutr. Cycl. Agroecosyst. 2011, 91, 173–184. [Google Scholar] [CrossRef]
- Muys, M.; Phukan, R.; Brader, G.; Samad, A.; Moretti, M.; Haiden, B.; Pluchon, S.; Roest, K.; Vlaeminck, S.E.; Spiller, M. A systematic comparison of commercially produced struvite: Quantities, qualities and soil-maize phosphorus availability. Sci. Total Environ. 2021, 756, 143726. [Google Scholar] [CrossRef]
- Chen, Y.; Rekha, P.D.; Arun, A.B.; Shen, F.T.; Lai, W.A.; Young, C.C. Phosphate solubilizing bacteria from subtropical soil and their tricalcium phosphate solubilizing abilities. Appl. Soil. Ecol. 2006, 34, 33–41. [Google Scholar] [CrossRef]
- Latif, A.; Jilani, G.; Hayat, R.; Khan, A.A.; Azeem, M.; Ehsan, M.; Mubarak, M.U. Isolation, characterization of PSB stains from rock phosphate and their potential as biofertilizer. Int. J. Biosci. 2017, 10, 72–80. [Google Scholar]
- Rodriguez, H.; Fraga, R. Phosphate solubilizing bacteria and their role in plant growth promotion. Biotechnol. Adv. 1999, 17, 319–339. [Google Scholar] [CrossRef]
- Jha, A.; Saxena, J.; Sharma, V. Investigation on phosphate solubilization potential of agricultural soil bacteria as affected by different phosphorus sources, temperature, salt, and pH. Commun. Soil Sci. Plant. Anal. 2013, 44, 2443–2458. [Google Scholar] [CrossRef]
- Yu., X.; Liu, X.; Zhu, T.H.; Liu, G.H.; Mao, C. Isolation and characterization of phosphate-solubilizing bacteria from walnut and their effect on growth and phosphorus mobilization. Biol. Fertil. Soils. 2011, 47, 437–446. [Google Scholar]
- Nosrati, R.; Owlia, P.; Saderi, H.; Rasooli, I.; Ali Malboobi, M. Phosphate solubilization characteristics of efficient nitrogen fixing soil Azotobacter strains. Iran. J. Microbiol. 2014, 6, 285–295. [Google Scholar]
- Schoebitz, M.; López, M.D.; Antonio Roldán, A. Bioencapsulation of microbial inoculants for better soil–plant fertilization. A review. Agron. Sustain. Dev. 2013, 33, 751–765. [Google Scholar]
- Hernández Jiménez, J.E.; Nyiraneza, J.; Fraser, T.D.; Brown, H.C.P.; Lopez-Sanchez, I.J.; Botero-Botero, L.R. Enhancing phosphorus release from struvite with biostimulants. Can. J. Soil Sci. 2021, 101, 22–32. [Google Scholar] [CrossRef]
- Bashan, Y.; Kamnev, A.A.; de-Bashan, L.E. Tricalcium phosphate is inappropriate as a universal selection factor for isolating and testing phosphate-solubilizing bacteria that enhance plant growth: A proposal for an alternative procedure. Biol. Fertil. Soils. 2013, 49, 465–479. [Google Scholar]
- Reyes, I.; Valery, A.; Valduz, Z. Phosphate-solubilizing microorganisms isolated from rhizospheric and bulk soils of colonizer plants at an abandoned rock phosphate mine. Plant Soil. 2006, 287, 69–75. [Google Scholar] [CrossRef]
- Ben Farhat, M.; Farhat, A.; Bejar, W.; Kammoun, R.; Bouchaala, K.; Fourati, A.; Antoun, H.; Bejar, S.; Chouayekh, H. Characterization of the mineral phosphate solubilizing activity of Serratia marcescens CTM 50650 isolated from the phosphate mine of Gafsa. Arch. Microbiol. 2009, 191, 815–824. [Google Scholar] [CrossRef] [PubMed]
- Kim, K.Y.; McDonald, G.A.; Jordan, D. Solubilization of hydroxyapatite by Enterobacter agglomerans and cloned Escherichia coli in culture medium. Biol. Fertil. Soils. 1997, 24, 347–352. [Google Scholar] [CrossRef]
- Bhatia, S.K.; Mehariya, S.; Bhatia, R.K.; Kumar, M.; Pugazhendhi, A.; Awasthi, M.K.; Atabani, A.E.; Kumar, G.; Kim, W.; Seo, S.-O.; et al. Wastewater based microalgal biorefinery for bioenergy production: Progress and challenges. Sci. Total Environ. 2021, 751, 141599. [Google Scholar]
- Gao, L.; Kong, F.; Feng, C.; Wang, J.; Gao, J.; Shen, G.; Zhang, C. Isolation, characterization, and growth promotion of phosphate-solubilizing bacteria associated with Nicotiana Tabacum (Tobacco). Pol. J. Environ. Stud. 2016, 25, 993–1003. [Google Scholar] [CrossRef]
- El-Brady, M.A.; Elbarbary, T.A.; Ibrahim, I.A.; Abdel-Fatah, Y.M. Azotobacter vinelandii evaluation and optimization of Abu Tartur Egyptian phosphate ore dissolution. Saudi J. Pathol. Microbiol. 2016, 1, 80–93. [Google Scholar]
- Nautiyal, C.S. An efficient microbiological growth medium for screening phosphate solubilizing microorganisms. FEMS Microbiol. Lett. 1999, 170, 265–270. [Google Scholar] [CrossRef] [PubMed]
- Goteti, P.K.; Desai, S.; Emmanuel, L.D.A.; Taduri, M.; Sultana, U. Phosphate solubilization potential of fluorescent Pseudomonas spp. isolated from diverse agro-ecosystems of India. Int. J. Soil Sci. 2014, 9, 101–110. [Google Scholar] [CrossRef][Green Version]
- Sitepu, I.R.; Hashidoko, Y.; Santoso, E.; Tahara, S. Potent phosphate-solubilizing bacteria isolated from dipterocarps grown in peat swamp forest in Central Kalimantan and their possible utilization for biorehabilitation of degraded peatland. In Proceedings of the International Symposium and Workshop on Tropical Peatland, Yogyakarta, Indonesia, 27–29 August 2007; pp. 27–29. [Google Scholar]
- Murphy, J.; Riley, J.P. A modified single solution method for the determination of phosphate in natural waters. Anal. Chim. Acta. 1962, 27, 31–36. [Google Scholar] [CrossRef]
- Joe, M.M.; Deivaraj, S.; Benson, A.; Henry, A.J.; Narendrakumar, G. Soil extract calcium phosphate media for screening of phosphate-solubilizing bacteria. Agric. Nat. Resour. 2018, 52, 305–308. [Google Scholar] [CrossRef]
- Baird, R.B. Standard Methods for the Examination of Water and Wastewater, 23rd ed.; Water Environment Federation; American Public Health Association; American Water Works Association: Denver, CO, USA, 2017. [Google Scholar]
- Rahman, M.; Salleh, A.; Rashid, U.; Ahsan, A.; Hossain, M.; Ra, C. Production of slow-release crystal fertilizer from wastewaters through struvite crystallization—A Review. Arab. J. Chem. 2014, 7, 139–155. [Google Scholar]
- Bower, C.E.; Holm-Hansen, T. A salicylate-hypochlorite method for determining ammonia in seawater. Can. J. Fish. Aquat. Sci. 1980, 37, 794–798. [Google Scholar] [CrossRef]
- Afzaal, M.; Khan, A.U.; Saeed, F.; Ahmed, A.; Ahmad, M.H.; Maan, A.A.; Tufail, T.; Anjum, F.M.; Hussain, S. Functional exploration of free and encapsulated probiotic bacteria in yogurt and simulated gastrointestinal conditions. Food Sci. Nutr. 2019, 7, 3931–3940. [Google Scholar] [PubMed]
- Marra, L.M.; de Oliveira-Longatti, S.M.; Soares, C.R.F.S.; de Lima, J.M.; Olivares, F.L.; Moreira, F.M.S. Initial pH of medium affects organic acids production but do not affect phosphate solubilization. Braz. J. Microbiol. 2015, 46, 367–375. [Google Scholar] [CrossRef] [PubMed]
- Talboys, P.J.; Heppell, J.; Roose, T.; Healey, J.R.; Jones, D.L.; Withers, P.J. Struvite: A slow-release fertilizer for sustainable phosphorus management? Plant Soil 2016, 401, 109–123. [Google Scholar] [PubMed]
- Chen, W.; Yang, F.; Zhang, L.; Wang, J. Organic acid secretion and phosphate solubilizing efficiency of Pseudomonas sp. PSB12: Effects of phosphorus forms and carbon sources. Geomicrobiol. J. 2016, 33, 870–877. [Google Scholar] [CrossRef]
- Illmer, P.; Schinner, F. Solubilization of inorganic calcium phosphates—Solubilization mechanisms. Soil Biol. Biochem. 1995, 27, 257–263. [Google Scholar] [CrossRef]
- Prabhu, N.; Borkar, S.; Garg, S. Chapter 11—Phosphate solubilization by microorganisms: Overview, mechanisms, applications and advances. In Advances in Biological Science Research: A Practical Approach; Meena, S.N., Naik, M.M., Eds.; Academic Press: London, UK, 2019; pp. 161–176. [Google Scholar]
- Ali, M.I.; Schneider, P.A.; Hudson, N. Thermodynamics and solution chemistry of struvite. J. Indian Inst. Sci. 2005, 85, 141–149. [Google Scholar]
- Shim, S.; Won, S.; Reza, A.; Kim, S.; Ahmed, N.; Ra, C. Design and optimization of fluidized bed reactor operating conditions for struvite recovery process from Swine Wastewater. Processes 2020, 8, 422. [Google Scholar]
- Tarrago, E.; Puig, S.; Ruscalleda, M.; Balaguer, M.D.; Colprim, J. Controlling struvite particles’ size using the up-flow velocity. Chem. Eng. J. 2016, 302, 819–827. [Google Scholar] [CrossRef]
- Kang, S.-M.; Radhakrishnan, R.; You, Y.-H.; Joo, G.-J.; Lee, I.-J.; Lee, K.-E.; Kim, J.-H. Phosphate solubilizing Bacillus megaterium mj1212 regulates endogenous plant carbohydrates and amino acids contents to promote mustard plant growth. Indian J. Microbiol. 2014, 54, 427–433. [Google Scholar] [CrossRef]
- Yan, Z.; Zheng, X.-W.; Chen, J.-Y.; Han, J.-S.; Han, B.-Z. Effect of different Bacillus strains on the profile of organic acids in a liquid culture of Daqu. J. Inst. Brew. 2019, 119, 78–83. [Google Scholar] [CrossRef]
- Bolan, N.S.; Naidu, R.; Mahimairaja, S.; Baskaran, S. Influence of low-molecular-weight organic acids on the solubilization of phosphates. Biol. Fertil. Soils. 1994, 18, 311–319. [Google Scholar] [CrossRef]
- Chien, M.; Nakahata, R.; Ono, T.; Miyauchi, K.; Endo, G. Mercury removal and recovery by immobilized Bacillus megaterium MB1. Front. Chem. Sci. Eng. 2012, 6, 192–197. [Google Scholar] [CrossRef]
- Wiwattanapatapee, R.; Chumthong, A.; Pengnoo, A.; Kanjanamaneesathian, M. Preparation and evaluation of Bacillus megaterium-alginate microcapsules for control of rice sheath blight disease. World J. Microbiol. Biotechnol. 2013, 8, 1487–1497. [Google Scholar]
- Hertzberger, A.J.; Cusick, R.D.; Margenot, A.J. A review and meta-analysis of the agricultural potential of struvite as a phosphorus fertilizer. Soil Sci. Soc. Am. J. 2020, 84, 653–671. [Google Scholar]
Publisher’s Note: MDPI stays neutral with regard to jurisdictional claims in published maps and institutional affiliations. |
© 2022 by the authors. Licensee MDPI, Basel, Switzerland. This article is an open access article distributed under the terms and conditions of the Creative Commons Attribution (CC BY) license (https://creativecommons.org/licenses/by/4.0/).